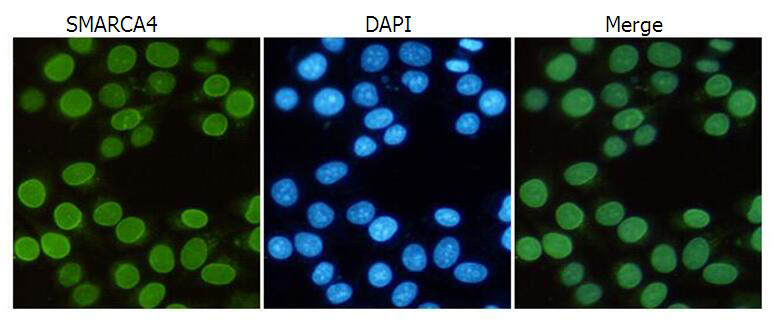

Background:
The protein encoded by this gene is a member of the SWI/SNF family of proteins and is similar to the brahma protein of Drosophila. Members of this family have helicase and ATPase activities and are thought to regulate transcription of certain genes by altering the chromatin structure around those genes. The encoded protein is part of the large ATP-dependent chromatin remodeling complex SNF/SWI, which is required for transcriptional activation of genes normally repressed by chromatin. In addition, this protein can bind BRCA1, as well as regulate the expression of the tumorigenic protein CD44. Mutations in this gene cause rhabdoid tumor predisposition syndrome type 2. Multiple transcript variants encoding different isoforms have been found for this gene.
Applications:
WB, IF, IP
Name of antibody:
SMARCA4
Immunogen:
Fusion protein of human SMARCA4
Full name:
SWI/SNF related, matrix associated, actin dependent regulator of chromatin, subfamily a, member 4
Synonyms:
BRG1; CSS4; SNF2; SWI2; MRD16; RTPS2; BAF190; SNF2L4; SNF2LB; hSNF2b; BAF190A
SwissProt:
P51532
WB Predicted band size:
185 kDa
WB Positive control:
K562, F9 and Hela NE cell lysates
WB Recommended dilution:
1000-5000
IF positive control:
Hela cells
IF Recommend dilution:
25-50
技術規格

購物車
購物車 幫助
幫助
 021-54845833/15800441009
021-54845833/15800441009
